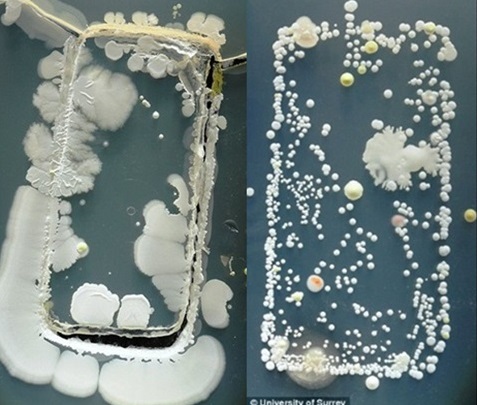
키뉴스

현대인의 필수품 휴대폰! 24시간 항상 몸에 지니고 다니면서 이메일, 친구들과의 전화, SNS 체크를 한다.
심지어 화장실에 들어가서 ‘작고 큰일들을’ 볼 때도 휴대폰을 본다.
대부분의 사람들이 아무 생각없이 화장실에서 휴대폰을 본다.
하지만 생각보다 이것이 우리에게 해로운 사실을 알고있는가?
우리가 무심코 화장실에 가져간 휴대폰은 사방에 잇는 무수한 균에 노출이 된다.
또한 전문가들은 우리가 화장실을 사용할 때 균이 사방으로 튄다고 경고한다.
그래서 화장실 어느 부분이나 모두 균이 존재한다고 한다.
특히 변기 핸들, 바닥에 균, 수도꼭지, 문 손잡이 등에 균이 많다고 한다.
개인 집의 화장실이 아닌 공중 화장실일 경우 더욱 많은 균이 존재한다고 한다.
포브스의 각종 연구 결과, 기준 면적 1인치²(1인치=2.5센티미터) 당 평균 가정집 화장실 변기의 박테리아 수는 50~300마리이다.
하지만 공공장소에서는 1000마리 이상인 것으로 조사됐다.
가정집 화장실이나 공중화장실 모두 휴대폰을 들고 간다면 이러한 박테리아에 노출이 된다는 것이다.
특히 스마트폰에는 대장균과 그 배설물은 물론이고 연쇄상구균, 황색포도상구균까지 서식하는 것으로 조사됐다.
우리는 화장실을 갔다 와서 손을 씻을 수 있지만 휴대폰은 물로 씻을 수 없으니, 아무리 우리가 손을 깨끗이 씻어도 휴대폰을 다시 만지면 우리는 다시 균에 노출되는 것이다.
전문가들은 변기보다 더러운 휴대폰을 깨끗하게 유지하려면 화장실 갈 때에는 두고 가고, 핸드폰을 위생 화장지 등을 사용해 자주 스마트폰 표면을 닦아주는 게 좋다고 조언하고 있다.
여러분의 주의에 화장실을 갈 때 핸드폰 들고 가는 사람이 있나요?
또는 이런 사실을 몰랐다면, 이 충격 이야기를 공유해주세요!